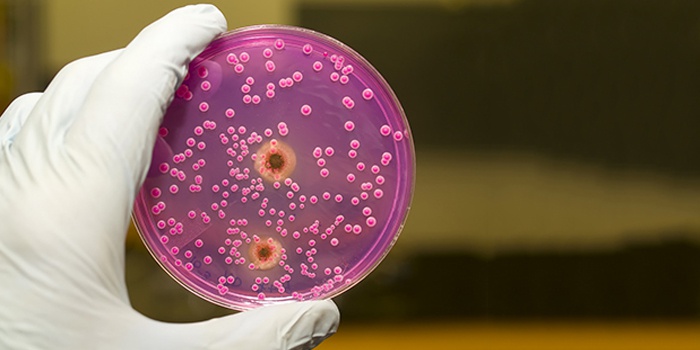

Препарат относится к группе противогрибковых медикаментов, назначается для лечения и профилактики заболеваний, вызванных этими микроорганизмами.
Терапевтический эффект от Флуконазола при молочнице классифицируют как высокоспецифичный. Главный действующий компонент подавляет жизнедеятельность патогенных грибов путем блокирования обмена веществ чужеродных органических соединений.
Это останавливает превращение тетрацикличного тритерпиноида в клетки мембранных грибов. Таким образом, существующие мембраны становятся уязвимыми к действию лекарства, прекращают расти, и утрачивают способность к восстановлению.
Преимущество препарата Флуконазол перед аналогами в том, что он действует только на патогенные грибы, и не затрагивает собственную микрофлору организма.
Особенно активен препарат при борьбе со спорофитами, вызванными бактериями рода Candida, в том числе и системный, диссеминированный кандидоз, возникающий при иммунодепрессии.
Если врач назначил при молочнице Флуконазол, его можно приобрести в разных формах: таблетки, капсулы, средство для инъекций.
Выпускают три вида дозировок: 50, 100 и 150 миллиграмм. Таблетки имеют специальное пленочное покрытие. Инъекционный раствор представляет собой ампулы из прозрачного стекла в дозировке 2 мг/мл.
Каждая таблетка 50 и 150 миллиграмм препарата содержит соответствующее количество Флуконазола (активный компонент). Из дополнительных веществ в составе присутствуют: крахмал, лактоза, магния стеарат, тальк, повидон и кроскармеллоза натрия.
Капсулы 100 миллиграмм содержат активный компонент (Флуконазол) в соответствующей дозировке. Из дополнительных веществ имеются: желатин, титана диоксид, хинолиновый краситель желтого цвета.
Если при молочнице Флуконазол приобретается в дозировке 50 и 150 миллиграмм, то препарат содержит соответствующую концентрацию основного компонента. Крышечка и основание капсулы отличаются по цветам (желтый и белый соответственно), внутри находится порошок в виде гранул белого, иногда желтого цвета.
Принимать Флуконазол следует после консультации с врачом, что обусловлено наличием ряда противопоказаний:
- организм имеет склонность к аллергическим реакциям на компоненты препарата;
- при постоянном приеме Флуконазола в суточной дозировке 400 и более миллиграмм совместно с терфенадином возникает конфликт;
- если пациенту назначено лечение лекарствами, удлиняющими интервал QT;
- при кормлении грудью;
- если возраст пациента не достиг четырех лет.
Флуконазол при молочнице с особой осторожностью назначается пациентам, у которых имеются следующие патологии: почечная или печеночная недостаточность (их комплекс), алкоголизм, хронические заболевания сердечной системы.
В период беременности и при лечении медикаментами патологического нарушения сердечного ритма прием Флуконазола при молочнице может осуществляться только после назначения врачом.
Внимание
Препарат может вызывать осложнения и нарушение работы некоторых систем организма.
Дисбаланс в работе желудочно-кишечного тракта: отсутствие аппетита, изменение вкусовых ощущений, болезненность в области живота, тошнота, рвота, диарея. В исключительных случаях могут пострадать функции печени.
Расстройства нервной системы: быстрая утомляемость и чувство общей слабости, обморочные состояния, головокружение и головные боли, крайне редко бывают судороги конечностей.
При наличии патологий сосудистой системы осложнения бывают следующие: снижение показателей лейкоцитов, резкое снижение количества красных частиц в составе крови, снижение показателей нейтрофильных гранулоцитов.
Побочные эффекты в виде аллергических проявлений: высыпания на коже различного характера, отечность, чувство зуда и жжения.
При патологиях сердечной системы возможно усиление аритмии, переход заболевания в форму мерцательной.
Принимая Флуконазол при молочнице, пациенты отмечают и прочие побочные действия: гипокалиемия, алопеция, гиперхолестеринемия.
Флуконазол при молочнице: как принимать в комплексной терапии и для профилактики заболевания
Препарат широкого противогрибкового спектра действия врачи назначают для подавления жизнедеятельности патогенных микроорганизмов, при борьбе с инфекционными заболеваниями, вызванными дрожжевыми грибами.
Используется в терапии криптококкового менингита, включая различные локализации патологии (кожные покровы, внутренние органы, легкие).
Эффективность терапии одинакова при лечении пациентов с нормальным и угнетенным иммунным ответом (после пересадки внутренних органов, оперативных вмешательств или при СПИДе). Также пациентам со СПИДом назначают Флуконазол в профилактических целях для предупреждения инфицирования криптококковыми бактериями.
Для лечения генерализованной формы генитального кандидоза, в том числе при наличии возбудителя заболевания в составе крови, при стремительном размножении грибков рода кандида и других проникающих формах заболевания (при поражении эндокарда, брюшной полости, дыхательных и мочевыводящих путей, глаз).
Не противопоказано лечение пациентов, у которых диагностированы образования злокачественного характера, при выполнении интенсивной терапии, проходящих курсовое лечение цитостатиками.
Флуконазол назначают, если диагностирована молочница слизистых оболочек (полости рта или глотки), включая ситуации, когда заболевание спровоцировано регулярным ношением зубных протезов. Терапия препаратом показана при поражении пищевода, бронхов, легких и кожных покровов. Также назначается пациентам с диагностированным СПИДом в целях профилактики развития орофарингеального кандидоза.
Флуконазол при молочнице назначают для лечения генитального и вагинального кандидоза острого и хронического течения. В комплексе профилактической терапии по развитию указанных заболеваний, и для снижения частоты рецидивов.
Высокая эффективность препарата отмечена при лечении следующих заболеваний: микоз (кожи, стопы, тела, области паха), грибок ногтей, отрубевидный лишай. Также назначается Флуконазол пациентам, прошедшим курс лучевой или химиотерапии.
При назначении препарата Флуконазол при молочнице, как принимать его в составе комплексной терапии может рекомендовать только лечащий врач. Согласно клинической картине следует регулярно принимать таблетки или капсулы препарата в любое удобное время суток, вне зависимости от приема пищи. Препарат в любом случае не потеряет и не снизит своей эффективности.
Особое внимание следует уделить терапии, если совместно проводится прием лекарственных средств, относящихся к группе антибиотиков. Зачастую, врачи принимают решение о необходимости совместного приема препаратов только при условии, что пациент находится в тяжелом состоянии, или инфекция трудно поддается лечению.
Особенность Флуконазола заключается в том, что он усиливает действие антибиотиков, это приводит к большему воздействию препарата на все системы организма больного. В некоторых случаях такое действие может негативно сказаться на процессе лечения.
На форуме пациенты, которые прошли курсовую терапию препаратом, оставляют только положительные отзывы. Однако необходимо четко следовать врачебным рекомендациям и придерживаться инструкции по применению.
Существует стандартная схема рассказывающая, как при молочнице принимать Флуконазол. Она незначительно отличается в зависимости от типа заболевания, пола и возраста пациента. Если врач четко выставил диагноз, и определил, что заболевание носит грибковый характер, то зачастую всем пациентам назначают Флуконазол. Это обусловлено высокой эффективностью препарата в борьбе с инфекциями. Если есть необходимость усилить действие, то в терапию включают вагинальные свечи и спреи.
Когда поражение вагинальным кандидозом произошло впервые, для лечения прописывают препарат в форме таблеток. Первичная дозировка составляет 150 миллиграмм в сутки. Курс лечения длится 1 день. Во избежание рецидива повторение процедуры рекомендуется спустя 7–14 дней.
Если указанная доза не принесла желаемого результата, и заболевание продолжает прогрессировать длительное время, схема меняется: первый прием препарата в дозировке 150 миллиграмм, затем три дня отдыха, далее снова прием лекарства, и так 14 дней. Далее продолжать прием по одной таблетке раз в месяц в течение полугода.
Если вам прописали Флуконазол при молочнице, как принимать его при хроническом течении болезни, описано ниже:
- Прием одной капсулы или таблетки в дозировке 150 миллиграмм (при молочнице после антибиотиков).
- Если не помогло, прием еще одной таблетки в такой же дозировке.
- При отсутствии эффекта еще одну таблетку в дозе 150 миллиграмм.
Данную схему лечения можно практиковать женщинам в период постменопаузы и при иммунной недостаточности.
Можно практиковать недельный курс лечения (дозировка 150 мг/сутки) или принимать по одной капсуле в день с промежутками 2, 3 и 5 суток. Если хроническое течение наблюдается несколько лет, то для подавления патогенной микрофлоры и профилактики рекомендуется прием одной таблетки или капсулы в неделю на протяжении шести месяцев.
Помимо этого есть рекомендации к профилактическому приему препарата Флуконазол при молочнице. Как принимать расскажет врач, или можно воспользоваться стандартной схемой: 150 миллиграмм в сутки, затем перерыв две недели, снова 150 миллиграмм в сутки, перерыв 1 месяц и еще один прием такой же дозы препарата.
Врачи отмечают, что флуконазол является одним из наиболее эффективных противогрибковых препаратов для лечения молочницы, вызванной грибами рода Candida. Его действие основано на подавлении синтеза эргостерола, что приводит к разрушению клеточной мембраны грибов. Многие специалисты подчеркивают, что флуконазол обладает высокой биодоступностью и может применяться как в виде таблеток, так и в виде растворов для инъекций.
Исследования показывают, что однократная доза флуконазола может быть достаточно эффективной для устранения симптомов молочницы, что делает его удобным вариантом для пациентов. Однако врачи также предупреждают о необходимости предварительной диагностики, так как не все случаи молочницы требуют применения противогрибковых средств. Важно учитывать индивидуальные особенности пациента, включая наличие сопутствующих заболеваний и возможные аллергические реакции. В целом, флуконазол остается популярным выбором среди врачей благодаря своей эффективности и удобству в применении.

Флуконазол: инструкция по применению при молочнице у детей и в период беременности
Как гласит инструкция по применению, Флуконазол при молочнице детям не назначают до достижения четырехлетнего возраста.
Длительность терапии у детей во многом зависит от положительной динамики.
Суточная доза не должна превышать 400 миллиграмм, но принимать лекарство следует не чаще одного раза в 24 часа.
Если у ребенка диагностирована молочница, дозировку препарата рассчитывают, опираясь на массу тела (6 мг/кг) для лечения пациента в первый день, в последующий период доза снижается до 3 мг/кг. В зависимости от степени тяжести молочницы, длительность лечения 2 недели и более.
При необходимости провести терапию криптококкового менингита у пациентов младшей возрастной группы, инструкция по применению Флуконазола при молочнице указывает на увеличение дозировки: первый день 12 мг/кг веса, и в последующие дни 6 мг/кг веса. Продолжительность лечения основывается на данных клинических анализов, в среднем от 10 до 14 недель, пока признаки возбудителя инфекции полностью не исчезнут.
Внимание
В исключительных случаях допускается лечение детей первого года жизни Флуконазолом.
Для младенцев первых двух недель жизни дозировка рассчитывается по приведенной выше схеме, при этом перерыв между введением лекарства составляет трое суток. В возрасте 2–4 недель частотность введения допускается с промежутком в 48 часов.
Во время терапии следует помнить, что закрепить полученный результат удастся только при прохождении всего курса лечения, даже если улучшения были заметны сразу.
Дозу для профилактики грибковой инфекции группы Candida врач назначает самостоятельно.
Если женщина решит принимать в период беременности Флуконазол, инструкция по применению при молочнице подобные действия запрещает. Прием возможен только при условии, что потенциальная польза в несколько раз превышает возможный вред, который препарат нанесет плоду.
У женщин в период вынашивания ребенка, исследований влияния препарата на плод не проводили. Статистика указывает на то, что у матерей, принимавших Флуконазол на протяжении 3 месяцев, рождались дети с врожденными патологиями.
Если есть необходимость провести лечение кандидоза ротовой полости в период лактации, нужно приостановить грудное вскармливание. Длительность лечения составляет от 7 до 14 дней, в дозировке 50 или 100 миллиграмм.
При сниженном иммунитете курс лечения увеличивается. Если диагностирована молочница полости рта, вызванная ношением протезов и систем коррекции зубов или прикуса, рекомендуемая доза 50 мг/сутки, при этом нужно выполнять регулярную обработку протезов антисептическим раствором.
Чаще всего врач самостоятельно, после изучения состояния пациента и получения анализов, определяет схему и длительность приема препарата Флуконазол. Инструкция по применению при молочнице указывает на то, что лекарство пьют раз в сутки до тех пор, пока не исчезнут симптомы болезни. Во избежание возникновения конфликта между препаратами, пациенту следует уведомить врача о том, какие лекарства он принимает в настоящий момент.
Характерные симптомы молочницы после приема противогрибкового средства уходят спустя 2–3 дня лечения. Для проверки эффективности и четкого определения, что влагалищный кандидоз вылечен, нужно сдать анализ на микрофлору.
В продаже также имеется Флуконазол-Тева, который имеет такой же действующий компонент, что и Флуконазол. Отличается только производителем и стоимостью. Цена за капсулу с дозировкой 150 миллиграмм составляет 170 рублей, а 50 миллиграмм — 250 рублей.
Препарат имеет широкий ряд аналогов, схожих по действию, но менее эффективных: Дифлазон, Флузон, Дифлюкан, Кандизол и прочие.
Цена Флуконазола в разных аптеках России начинается от 11 рублей, что делает его доступным для приобретения пациентам с различным уровнем достатка.
Флуконазол — это противогрибковый препарат, который часто назначают для лечения молочницы, вызванной грибами рода Candida. Многие пациенты отмечают его высокую эффективность и быстрое действие. Обычно достаточно однократного приема таблетки, чтобы облегчить симптомы, такие как зуд и дискомфорт.
Пользователи также подчеркивают удобство применения: не требуется длительный курс лечения, что особенно важно для занятых людей. Однако некоторые отмечают побочные эффекты, такие как головная боль или расстройства пищеварения. Важно помнить, что перед началом лечения стоит проконсультироваться с врачом, чтобы исключить возможные противопоказания и подобрать оптимальную дозировку. В целом, Флуконазол зарекомендовал себя как надежное средство в борьбе с молочницей, что подтверждают положительные отзывы пациентов.
Флуконазол для мужчин — схема лечения молочницы и профилактический прием
Молочница у представителей сильного пола — это довольно редкое заболевание.
Чаще всего она возникает при прогрессировании сопутствующих патологий: сниженной иммунной функции, наличии избыточного веса, сахарного диабета и ВИЧ.
Основными местами локализации грибковой инфекции выступает ротовая полость и слизистая оболочка половых органов.
Для мужчин Флуконазол показан, если проявляются следующие симптомы: зуд, отечность, жжение, покраснение полового члена, наличие белого налета на органе.
При возникновении подозрения на молочницу, обязательно необходима консультация врача. Он точно сможет определить тип грибковой инфекции или дифференцирует заболевание.
Если требуется лечение молочницы для мужчин, флуконазол назначают по следующей схеме:
- генитальный кандидоз — 1 капсула (150 миллиграмм) в сутки, единоразово, при условии наличия ярких симптомов и большого количества налета;
- для лечения длительно текущих заболеваний — на протяжении четырех месяцев прием одной капсулы Флуконазола (100 миллиграмм) раз в неделю;
- если заболевание выявлено на ранней стадии, Флуконазол для мужчин назначают в виде крема (можно комбинировать с приемом идентичных таблеток).
В профилактических целях мужчинам рекомендуется принимать Флуконазол в капсулах с дозировкой 150 миллиграмм 1 раз в месяц.
Молочница — это серьезная грибковая инфекция, которая в запущенных случаях тяжело поддается лечению. Если есть подозрения на развитие заболевания, обязательно необходимо обратиться к гинекологу или урологу и сдать биологические материалы на исследование. Только после этого терапия будет эффективной и непродолжительной.

Вопрос-ответ
Сколько нужно пить флуконазол, чтобы вылечить молочницу?
При остром вагинальном кандидозе, кандидозном баланите препарат применяют однократно внутрь в дозе 150 мг. Для снижения частоты рецидивов вагинального кандидоза препарат можно применять в дозе 150 мг через каждые три дня – всего 3 дозы (в 1-й, 4-й и 7-й день), затем поддерживающая доза 150 мг один раз в неделю.

Как быстро проходит молочница после приема флуконазола?
В среднем, уменьшения симптомов кандидозного вульвовагинита («молочницы») следует ожидать через 2 дня после приема препарата Флюкостат.
Как правильно принимать таблетки флуконазол для молочницы?
Острый вагинальный кандидоз, баланит, осложненный грибами рода Candida, Флуконазол назначают однократно внутрь в дозе 150 мг. Для предотвращения рецидивов вагинального кандидоза применяют 150 мг через каждые три дня – всего 3 дозы (в 1-й, 4-й и 7-й день), далее для поддержания по 150 мг 1 раз в неделю.
Как быстро наступает эффект от флуконазола?
Флуконазол обладает хорошей абсорбцией. Прием пищи не изменяет всасывание действующего вещества. Наибольшее содержание в крови отмечается через 4 часа при приеме внутрь и через 0, 5–1, 5 часа после инфузии. Период выведения — 30 часов.
Советы
СОВЕТ №1
Перед началом лечения флуконазолом обязательно проконсультируйтесь с врачом. Самолечение может привести к неправильной дозировке и ухудшению состояния.
СОВЕТ №2
Обратите внимание на возможные побочные эффекты. Если вы заметили необычные реакции организма, такие как сыпь, головная боль или расстройства пищеварения, немедленно сообщите об этом врачу.
СОВЕТ №3
Следуйте предписанной схеме лечения и не прерывайте курс, даже если симптомы исчезли. Это поможет предотвратить рецидивы и развитие устойчивости грибков к препарату.
СОВЕТ №4
Помимо медикаментозного лечения, рассмотрите возможность изменения образа жизни: соблюдайте гигиену, избегайте стрессов и придерживайтесь сбалансированной диеты, чтобы поддерживать иммунную систему.